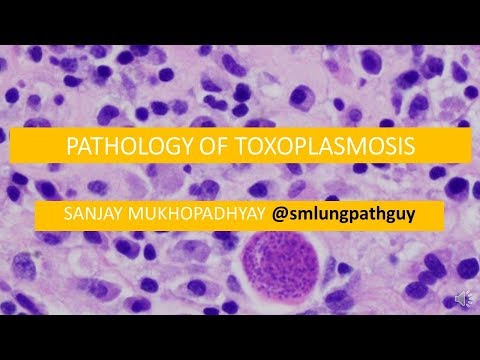
YouTube video

Sabitlenmiş Tweet

Current and former residents representing BCM pathology at Texas Society of Pathologists YPS retreat! @BCM_PathRes @bcmhouston @TexPathol


English
Marianne Beynon, MD
845 posts

@BeynonMD
2018-19 Forensic Pathology Fellow

Histiocytes in disseminated histoplasmosis #pulmpath #pathboards #cellfie @AmyHDeekenMD @JMGardnerMD @mannanrifat03





